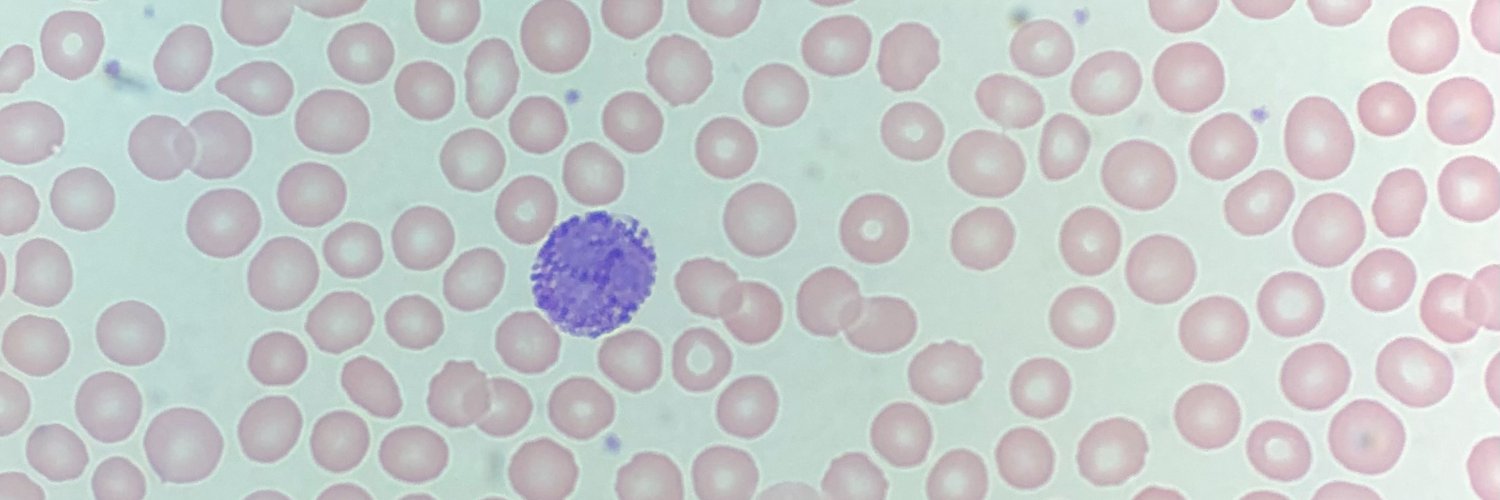
Amber M Yates, MD banner

Amber M Yates, MD
13.4K posts


Amber M Yates, MD
@sicklecelldoc
#twinmom, #RAWarrior #PHODoc #MedicalAffairs #SickleCell Tweets are not medical advice. she/her
Houston, TX Katılım Haziran 2014
1.9K Takip Edilen3K Takipçiler
Henüz tweet yok
Amber M Yates, MD
13.4K posts

@sicklecelldoc
#twinmom, #RAWarrior #PHODoc #MedicalAffairs #SickleCell Tweets are not medical advice. she/her
Henüz tweet yok